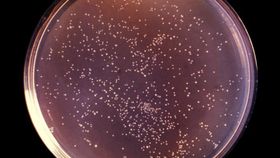

Scientists have documented the discovery of a new antimicrobial resistant strain of Yersinia pestis, the notorious bacteria that causes the plague, that's capable of spreading from human to human.
The rest of this article is behind a paywall. Please sign in or subscribe to access the full content.As reported in the journal Clinical Infectious Diseases, the strain was picked up during a pneumonic plague outbreak that took hold in the Faratsiho district of Madagascar back in February 2013. Using samples from this outbreak, scientists from Northern Arizona University and Institut Pasteur de Madagascar have recently analyzed the strain and confirmed it was resistant to streptomycin, a widely used antibiotic that’s considered the first-line “drug of choice” to treat plague.
Crucially, they also showed for the first time that this strain of antimicrobial-resistant plague can be transmitted person-to-person. A total of 22 people are thought to have been infected during this outbreak, three of whom died. The researchers argue that many of the 19 infected people who survived likely caught the disease during the traditional funeral practices for one or more of the three fatal cases.
“We determined – for the first time – that AMR strains of Y. pestis can be transmitted person-to-person,” Professor Dave Wagner from Northern Arizona University's Pathogen and Microbiome Institute said in a statement.
“The [antimicrobial resistant] AMR strain from this outbreak is resistant to streptomycin due to a spontaneous point mutation, but is still susceptible to many other antibiotics, including co-trimoxazole. Luckily, the 19 cases that were treated all received co-trimoxazole in addition to streptomycin, and all of them survived."
Antimicrobial-resistant plague has been seen before. For instance, in 2017, scientists reported the case of a 16-year-old boy in Madagascar who was infected with Y. pestis bacteria that was found to be resistant to eight common antibiotics used to treat the infection, including streptomycin. However, this is the first time researchers have found evidence of person-to-person spread.
Plague is often said to be one of the oldest and most lethal diseases in human history. Among its grimmest "achievements" was the Black Death, the pandemic that killed upwards of 50 million people in Eurasia and North Africa in the 14th century.
The disease comes in three forms of plague: bubonic, pneumonic, and septicaemic. Bubonic is the most common form of the disease and is most often transmitted to humans from the bite of a flea. Left untreated, it can progress to the lungs and become pneumonic plague, which is typically lethal if medical attention is not sought. Pneumonic plague is also considered more contagious and is spread person-to-person through droplets in the air. The plague still infects hundreds of people each year, primarily in rural parts of Asia and Africa. While rare in the “developed world,” odd cases are still seen in North America, most notably in remote areas in the western United States.
Serious outbreaks of plague remain rare in most parts of the world because it’s easy to treat with antimicrobial treatment – for now, at least. As this recent discovery shows, we might not always be able to rely on our current arsenal of antibiotics to treat once-easily curable diseases.
"The point mutation, which also is the source of streptomycin resistance in other bacterial species, has occurred independently in Y. pestis at least three times and appears to have no negative effect on the AMR strain, suggesting that it could potentially persist in nature via the natural rodent-flea transmission cycle. However, AMR Y. pestis strains are exceedingly rare and the mutation has not been observed again in Madagascar since this outbreak," Professor Wagner explained.